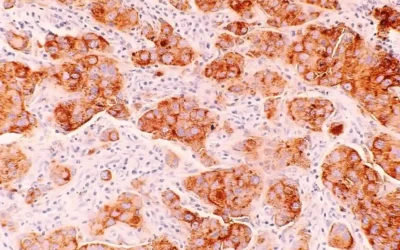
Aplicación tópica de exosomas de células madre mesenquimales derivadas del cordón umbilical para una quemadura profunda de segundo grado: informe de un caso

Últimas investigaciones y avances con células madre
Estudio evalúa la seguridad de productos derivados de sangre del cordón umbilical en síndrome de la articulación sacroilíaca
El estudio que se muestra a continuación no está realizado con sangre de cordón umbilical para uso autólogo eventual. Hoy en día la probabilidad de que una unidad de sangre del cordón autólogo sea...
Seguridad y resultados clínicos de las células progenitoras expandidas no injertadas de donantes agrupados en el trasplante de sangre de cordón umbilical de unidad única
El estudio que se muestra a continuación no está realizado con sangre de cordón umbilical para uso autólogo eventual. Hoy en día la probabilidad de que una unidad de sangre del cordón autólogo sea...
Aplicación tópica de exosomas de células madre mesenquimales derivadas del cordón umbilical para una quemadura profunda de segundo grado: informe de un caso
El estudio que se muestra a continuación no está realizado con sangre de cordón umbilical para uso autólogo eventual. Hoy en día la probabilidad de que una unidad de sangre del cordón autólogo sea...
Trasplante de sangre del cordón umbilical en niños con anemia de Diamond-Blackfan
El estudio que se muestra a continuación está realizado con sangre de cordón umbilical para uso emparentado. Hoy en día la probabilidad de que una unidad de sangre del cordón autólogo sea utilizada...
Ensayo PRIME-HFrEF: un régimen aleatorizado, doble ciego y de dosis múltiples de células madre mesenquimales derivadas del cordón umbilical para la insuficiencia cardíaca
El estudio que se muestra a continuación no está realizado con sangre de cordón umbilical para uso autólogo eventual. Hoy en día la probabilidad de que una unidad de sangre del cordón autólogo sea...
Curación completa tras terapia con exosomas derivados de células madre mesenquimales umbilicales para una fístula anal compleja
El estudio que se muestra a continuación no está realizado con sangre de cordón umbilical para uso autólogo eventual. Hoy en día la probabilidad de que una unidad de sangre del cordón autólogo sea...
Terapias basadas en células estromales mesenquimales alogénicas para las úlceras del pie diabético: Revisión sistemática y metaanálisis de ensayos controlados
El estudio que se muestra a continuación no está realizado con sangre de cordón umbilical para uso autólogo eventual. Hoy en día la probabilidad de que una unidad de sangre del cordón autólogo sea...
Inmunoterapia celular para el síndrome de dificultad respiratoria aguda inducido por COVID: resultados de los ensayos del estudio CIRCA-19
El estudio que se muestra a continuación no está realizado con sangre de cordón umbilical para uso autólogo eventual. Hoy en día la probabilidad de que una unidad de sangre del cordón autólogo sea...
Terapia con células mesenquimales del cordón umbilical para el trastorno del espectro de la neuromielitis óptica
El estudio que se muestra a continuación no está realizado con sangre de cordón umbilical para uso autólogo eventual. Hoy en día la probabilidad de que una unidad de sangre del cordón autólogo sea...
Viabilidad y seguridad de la terapia celular para la reparación intrauterina del mielomeningocele (ensayo CuRe)
El estudio que se muestra a continuación no está realizado con sangre de cordón umbilical para uso autólogo eventual. Hoy en día la probabilidad de que una unidad de sangre del cordón autólogo sea...
Exosomas de células madre mesenquimales del cordón umbilical en el cáncer de mama
El estudio que se muestra a continuación no está realizado con sangre de cordón umbilical para uso autólogo eventual. Hoy en día la probabilidad de que una unidad de sangre del cordón autólogo sea...
Seguridad y efectos funcionales exploratorios del suero tópico de sangre de cordón umbilical en pacientes con glaucoma
El estudio que se muestra a continuación no está realizado con sangre de cordón umbilical para uso autólogo eventual. Hoy en día la probabilidad de que una unidad de sangre del cordón autólogo sea...
Los estudios que se muestran a continuación están realizados con células de cordón umbilical alogénicas y algunos con células de cordón umbilical para uso autólogo eventual.
Hoy en día la probabilidad de que una unidad de sangre del cordón autólogo sea utilizada para trasplante es muy bajo y su utilización se ha limitado a patologías en pediatría, fundamentalmente en la aplasia medular adquirida, tumores sólidos de alto riesgo (neuroblastoma, sarcoma de Edwing, meduloblastoma y tumores germinales) y algunos linfomas no Hodgkin en segunda remisión. Actualmente no existe una evidencia clara de que estas células puedan ser utilizadas para la medicina regenerativa o para tratar otras enfermedades en el futuro. Hay varios ensayos clínicos iniciales para probar la eficacia de células autólogas para algunas indicaciones. Sin embargo en la actualidad es imposible predecir los resultados de la investigación que pueden afectar el potencial uso de estas células.
FUENTE: Sociedad Española de Hematología y Hemoterapia (SEHH)
Las noticias recogidas en la web, disponen del link a la publicación científica del estudio, para que puedas ampliar información.